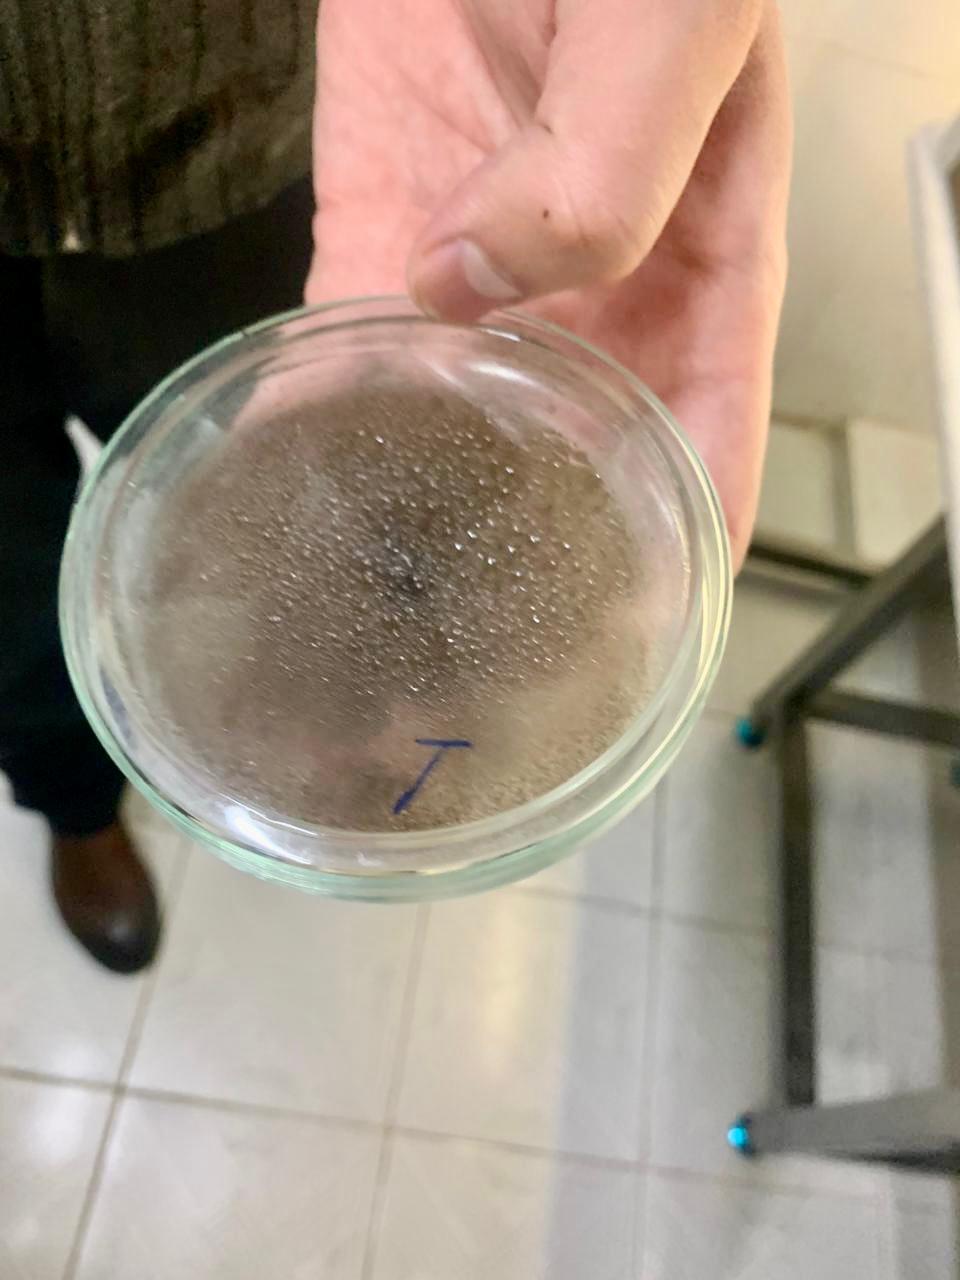

Жаңалықтар
Студенттер Ташкентте өндірістік практикадан өтті
- Қаралды: 76
М. Әуезов атындағы Оңтүстік Қазақстан университеті «Биотехнология» кафедрасының 6В05120 – Биотехнология білім беру бағдарламасының 2-курс студенттері Ташкент химия-технология институты «Биотехнология» кафедрасының базасында өндірістік практикадан өтті. Практика жетекшісі – Есимова Анар Маденовна.
Практика 2026 жылдың 26–30 қаңтары аралығында Ташкент қаласында ұйымдастырылды. Практика барысында студенттер биотехнология саласындағы заманауи зерттеу әдістерімен танысып, теориялық білімдерін тәжірибемен ұштастыруға мүмкіндік алды.
Сонымен қатар, студенттер Садыков атындағы Биоорганикалық химия ғылыми-зерттеу институтына барып, институттың зертханаларымен танысты. Онда жүргізіліп жатқан ғылыми-зерттеу жұмыстары, биотехнологиялық зерттеу бағыттары мен инновациялық жобалар туралы ақпарат алды. Институт мамандары студенттерге ғылыми тәжірибелердің жүргізілу барысын түсіндіріп, зертханалық құрал-жабдықтардың жұмыс істеу ерекшеліктерін көрсетті.
Аталған өндірістік практика студенттердің кәсіби дағдыларын дамытуға, ғылыми-зерттеу жұмыстарына қызығушылығын арттыруға зор мүмкіндік берді.
Практика 2026 жылдың 26–30 қаңтары аралығында Ташкент қаласында ұйымдастырылды. Практика барысында студенттер биотехнология саласындағы заманауи зерттеу әдістерімен танысып, теориялық білімдерін тәжірибемен ұштастыруға мүмкіндік алды.
Сонымен қатар, студенттер Садыков атындағы Биоорганикалық химия ғылыми-зерттеу институтына барып, институттың зертханаларымен танысты. Онда жүргізіліп жатқан ғылыми-зерттеу жұмыстары, биотехнологиялық зерттеу бағыттары мен инновациялық жобалар туралы ақпарат алды. Институт мамандары студенттерге ғылыми тәжірибелердің жүргізілу барысын түсіндіріп, зертханалық құрал-жабдықтардың жұмыс істеу ерекшеліктерін көрсетті.
Аталған өндірістік практика студенттердің кәсіби дағдыларын дамытуға, ғылыми-зерттеу жұмыстарына қызығушылығын арттыруға зор мүмкіндік берді.
Егер Сіз қатені байқасаңыз, мәтін бөлігін таңдап, Ctrl+Enter пернелерін басыңыз